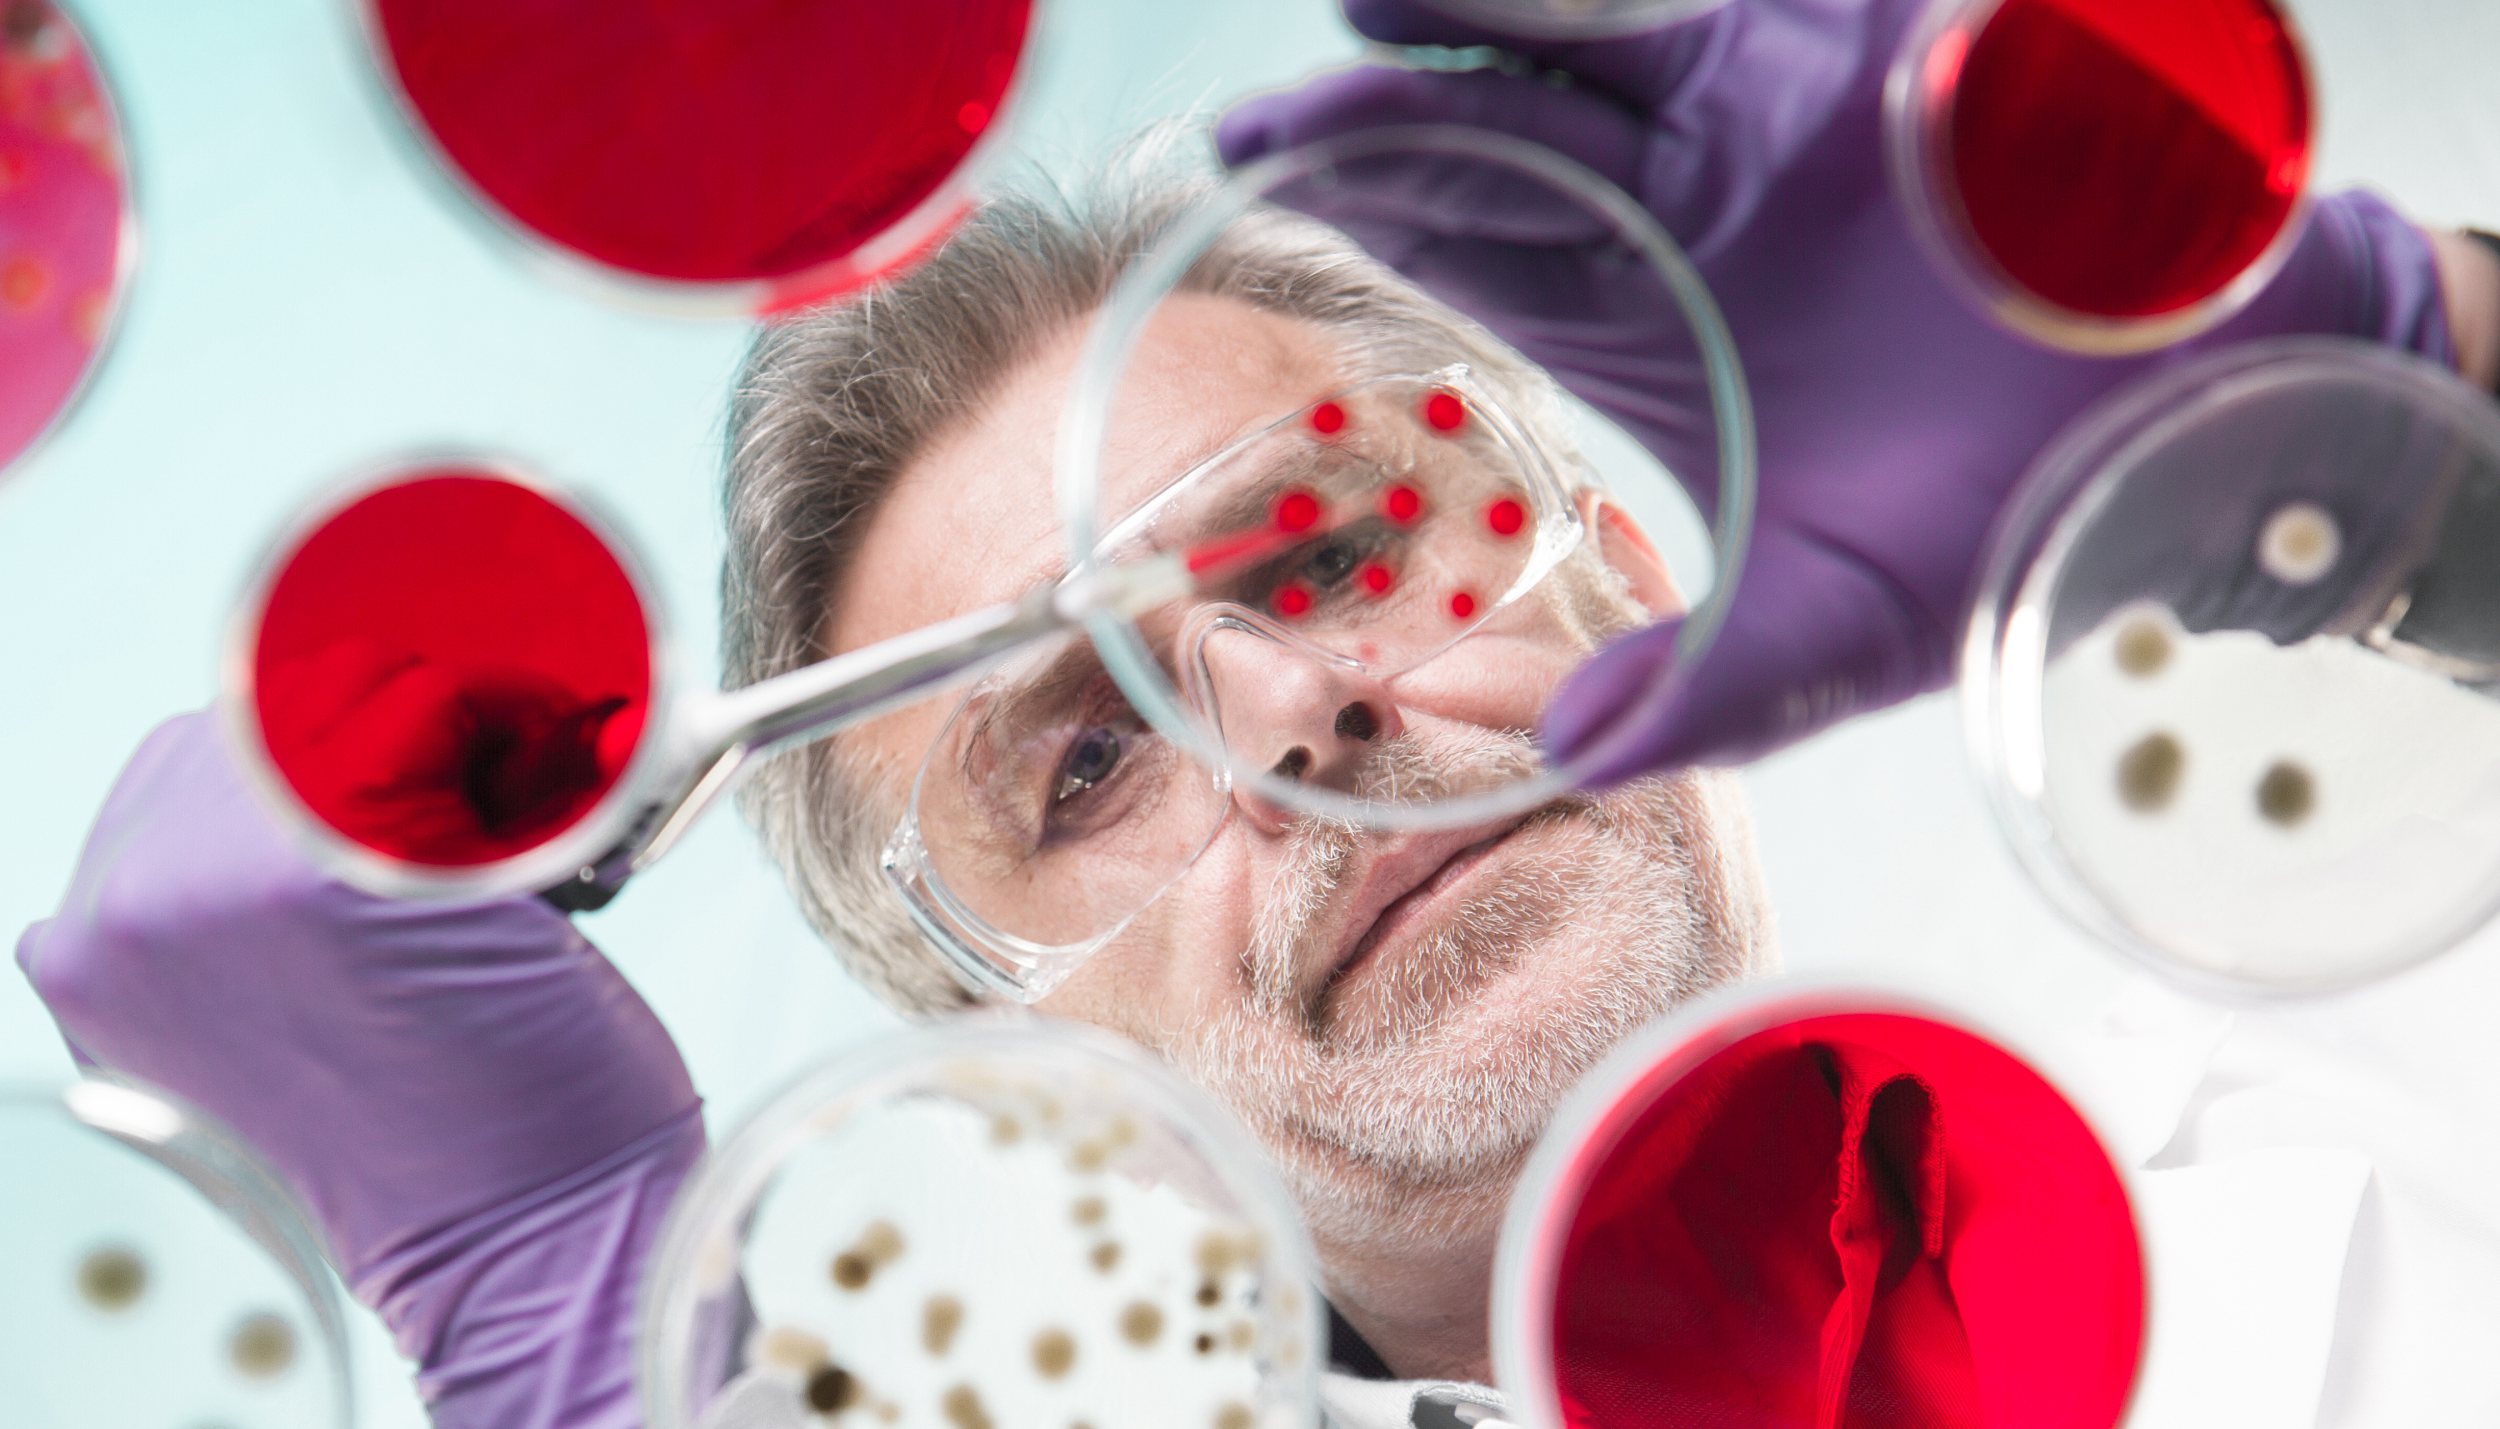

数月之间,已有多国研究人员确定了数百种新冠病毒变异。但尚无人断定这对病毒的防控意味着什么。
美国洛斯阿拉莫斯国家实验室的初步研究表明,新冠病毒2月份在欧洲出现的特殊突变——D614G——已迅速转移到了美国东海岸,自3月中旬以来一直是世界各地的主导病毒。这种特殊的变异似乎使得病毒的生长速度更快,传染性更强。
这份33页的报告于上周发布在BioRxiv网站上,是未经同行审阅的预印本。研究小组分析了英国谢菲尔德新冠病毒患者的数据。虽然携带这种变异病毒的患者体内存在更多病毒,但没有证据表明这些患者病情更严重,或者住院时间更长。
病毒发生变异并非罕见现象。例如流感病毒变异非常快,因此每年都有必要接种新的流感疫苗。病毒学家认为,到目前为止,新冠病毒的变异相对稳定,但在全世界的广泛传播给了它充分变异的机会。
针对洛斯阿拉莫斯国家实验室的研究结果,哈佛大学流行病学家威廉·汉纳吉(William Hanage)认为,当变异后的病毒到达意大利北部时,年龄较大的易感人群难以抵抗,才使得这种变异病毒成为主导。实际上这种突变没有影响病毒的感染力。
伦敦大学学院的另一项研究确定了198种新冠病毒突变。研究作者之一巴卢(Francois Balloux)指出,突变本身不是一件坏事,也没有迹象表明突变速度比预期中快或慢。“到目前为止,我们还不能断定病毒的致命性和传染程度越来越强,或越来越弱。”
《华盛顿邮报》援引部分专家指出,实际上,随着病毒在人群中传播和时间的推移,新冠病毒感染可能在多年后成为一种比较温和的疾病。
研究病毒变异同时也是疫苗开发的重要环节。各国正在研发的疫苗都针对于冠状病毒的独特“尖峰”——即新冠病毒用来入侵宿主细胞的棘突蛋白。如果“尖峰”出现较大改变,那么开发出来的疫苗效果将打折扣。
与此同时,即便变异病毒危险性没有增加,已经对原始病毒产生免疫力的康复患者可能对新的变异病毒没有免疫力,这可能导致同一人二次感染新冠病毒,加大了遏制传播的难度。
4月27日,世卫组织卫生紧急项目技术主管玛丽亚·范·科霍夫表示,到目前为止,新冠肺炎病毒相对稳定,有一些预期中RNA病毒会有的变化,但在预期范围内。此外不同国家发现的病毒,在传播能力或引起严重疾病的能力方面并没有差异。



评论